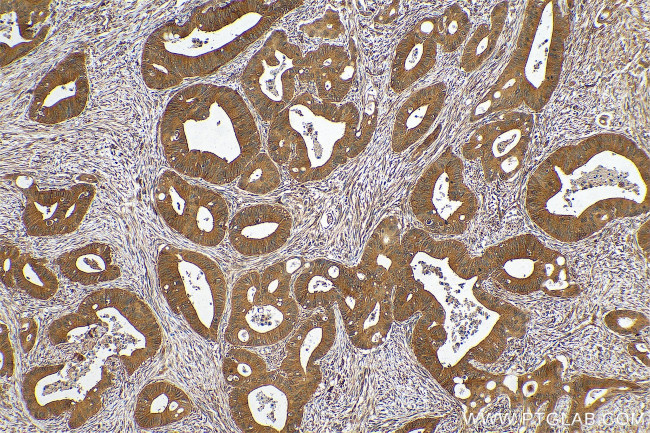
ERCC6L Antibody in Immunohistochemistry (Paraffin) (IHC (P))

Search
Proteintech
ERCC6L Polyclonal Antibody
{{$productOrderCtrl.translations['antibody.pdp.commerceCard.promotion.promotions']}}
{{$productOrderCtrl.translations['antibody.pdp.commerceCard.promotion.viewpromo']}}
{{$productOrderCtrl.translations['antibody.pdp.commerceCard.promotion.promocode']}}: {{promo.promoCode}} {{promo.promoTitle}} {{promo.promoDescription}}. {{$productOrderCtrl.translations['antibody.pdp.commerceCard.promotion.learnmore']}}
产品信息
15688-1-AP
种属反应
宿主/亚型
分类
类型
抗原
偶联物
形式
浓度
规格
纯化类型
保存液
内含物
保存条件
运输条件
产品详细信息
Immunogen sequence: NAESNVSII EIADDLSASH SALQDAQASE AKLEEEPSAS SPQYACDFNL FLEDSADNRQ NFSSQSLEHV EKENSLCGSA PNSRAGFVHS KTCLSWEFSE KDDEPEEVVV KAKIRSKARR IVSDGEDEDD SFKDTSSINP FNTSLFQFSS VKQFDASTPK NDISPPGRFF SSQIPSSVNK SMNSRRSLAS RRSLINMVLD HVEDMEERLD DSSEAKGPED YPEEGVEESS GEASKYTEED PSGETLSSEN KSSWLMTSKP SALAQETSLG APEPLSGEQL VGSPQDKAAE ATNDYETLVK RGKELKECGK IQEALNCLVK ALDIKSADPE VMLLTLSLYK QLNNN (110-454 aa encoded by BC008808)
靶标信息
ERCC6L is a DNA helicase that acts as an essential component of the spindle assembly checkpoint. ERCC6L contributes to the mitotic checkpoint by recruiting MAD2 to kinetochores and monitoring tension on centromeric chromatin. ERCC6L acts as a tension sensor that associates with catenated DNA which is stretched under tension until it is resolved during anaphase.
仅用于科研。不用于诊断过程。未经明确授权不得转售。
生物信息学
蛋白别名: ATP-dependent helicase ERCC6-like; DNA excision repair protein ERCC-6-like; excision repair cross-complementation group 6 like; excision repair cross-complementing rodent repair deficiency complementation group 6 - like; excision repair cross-complementing rodent repair deficiency, complementation group 6-like; excision repair protein ERCC6-like; FLJ20105; MGC131695; PLK1-interacting checkpoint helicase; SNF2 type translocase; SNF2/RAD54 family protein; Tumor antigen BJ-HCC-15; unnamed protein product
基因别名: ERCC6L; PICH; RAD26L
UniProt ID: (Human) Q2NKX8
Entrez Gene ID: (Human) 54821